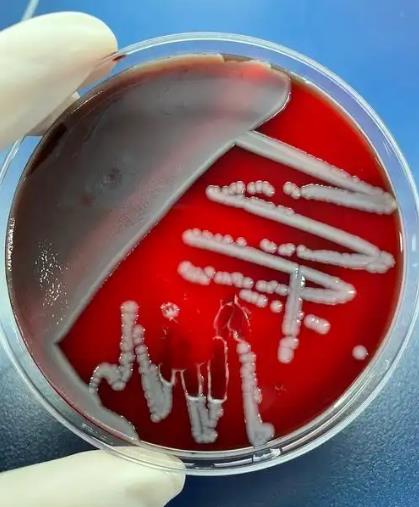
腸炎沙門菌親本株和毒力島基因缺失株的生長(zhǎng)曲線繪制

取培養(yǎng)至對(duì)數(shù)生長(zhǎng)期的CRABA,用無菌生理鹽水配制成0.5麥?zhǔn)蠞岫龋?00μL菌液分別加至巴西蘇木素濃度不同的100μL肉湯培養(yǎng)基中,使肉湯中巴西蘇 ...
歡迎來到BioSense網(wǎng)站!
歡迎來到BioSense網(wǎng)站!

取培養(yǎng)至對(duì)數(shù)生長(zhǎng)期的CRABA,用無菌生理鹽水配制成0.5麥?zhǔn)蠞岫龋?00μL菌液分別加至巴西蘇木素濃度不同的100μL肉湯培養(yǎng)基中,使肉湯中巴西蘇 ...

?摘要:目的探討蘇木及其活性成分對(duì)耐碳青霉烯類鮑曼不動(dòng)桿菌(CRABA)的殺菌作用及巴西蘇木素與美羅培南聯(lián)合抑菌作用。 ...

腦膜炎奈瑟菌又稱腦膜炎球菌,定植在人鼻咽部黏膜,可通過黏膜屏障引起流腦、侵襲性菌血癥或腦膜炎球菌肺炎。目前,全球范圍內(nèi)流腦病死率超過10%,伴高致殘率 ...

7株Y群Nm分離株對(duì)青霉素、氨芐西林、頭孢噻肟、頭孢曲松、美羅培南、氯霉素、阿奇霉素、米諾環(huán)素、利福平、環(huán)丙沙星、萘啶酸、左氧氟沙星12種抗菌藥物敏感 ...

流行性腦脊髓膜炎(epidemic cerebrospinal meningitis,ECM)簡(jiǎn)稱流腦,是由腦膜炎奈瑟菌(Neisseria meni ...

Cry1Ac蛋白不會(huì)對(duì)細(xì)菌造成毒性損傷;二元體系聯(lián)合暴露時(shí)Zn2+、Cd2+均與Cry1Ac蛋白(吲哚基團(tuán))結(jié)合,使得Zn2+、Cd2+對(duì)兩種細(xì)菌的毒 ...

本研究以Cry1Ac蛋白作為Bt蛋白代表,以Zn2+、Cd2+作為重金屬代表,以大腸桿菌(Escherichia coli)和枯草芽孢桿菌(Bacil ...

本研究以Cry1Ac蛋白作為Bt蛋白代表,以Zn2+、Cd2+作為重金屬代表,以大腸桿菌(Escherichia coli)和枯草芽孢桿菌(Bacil ...
為分析毒力島基因SPI-1和SPI-2缺失對(duì)腸炎沙門菌生物學(xué)特性、致病性和免疫原性的影響,本實(shí)驗(yàn)室前期構(gòu)建了腸炎沙門菌SM6株毒力島基因SPI-1和S ...

本研究在本實(shí)驗(yàn)室已構(gòu)建的DEV疫苗株細(xì)菌人工染色體感染性克隆pDEV-EF1的基礎(chǔ)上,通過“Red E/T兩步重組”技術(shù),構(gòu)建DEV gG基因缺失的感 ...